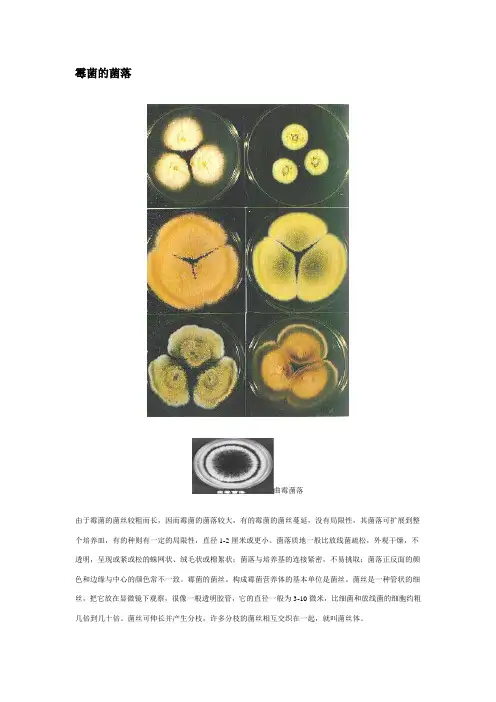

微生物菌落形态图片
- 格式:doc
- 大小:3.24 MB
- 文档页数:13

1、金黄色葡萄球菌金黄色葡萄球菌(Staphylococcus aureus ) ,典型的金黄色葡萄球菌为球形,直径0.8μm左右,显微镜下排列成葡萄串状。
金黄色葡萄球菌无芽孢、鞭毛,大多数无荚膜,革兰氏染色阳性。
是一种不利于人体的细菌。
金黄色葡萄球菌营养要求不高,在普通培养基上生长良好,需氧或兼性厌氧,最适生长温度37℃,最适生长pH 7.4。
平板上菌落厚、有光泽、圆形凸起,直径1-2mm。
血平板菌落周围形成透明的溶血环。
金黄色葡萄球菌有高度的耐盐性,可在10%-15%NaCl肉汤中生长。
可分解葡萄糖、麦芽糖、乳糖、蔗糖,产酸不产气。
在干燥环境中存活数月;空气中存在,但不繁殖。
耐热性强,加热70℃1h,80℃30min不被杀死;耐低温,在冷冻食品中不易死亡;耐高渗,在含有50%-66%蔗糖或15%以上食盐食品中才可被抑制,能在15%NaCl和40%胆汁中生长。
金黄色葡萄球菌具有较强的抵抗力,对磺胺类药物敏感性低,但对青霉素、红霉素等高度敏感。
有金黄色葡萄球菌感染者,可选用:红霉素、新型青霉素、庆大霉素、万古霉素或先锋霉素Ⅵ治疗。
2、铜绿假单胞菌铜绿假单胞菌(P.Aeruginosa)原称绿脓杆菌。
在自然界分布广泛,为土壤中存在的最常见的细菌之一。
各种水、空气、正常人的皮肤、呼吸道和肠道等都有本菌存在。
本菌存在的重要条件是潮湿的环境。
铜绿假单胞菌的学名是Pseudomonas aeruginosa,当中的Pseudomonas是由希腊语的pseudo及monas所组成,意即虚假的单元,是早期微生物学用作描述病菌的。
而Aeruginosa 则是铜绿(即铜与空气中的氧气、二氧化碳和水等物质反应产生的物质,又称铜锈。
化学式Cu2(OH)2CO3),正好表达了这种细菌所产生的青色色素。
绿脓素(pyocynin)的生物合成是以群体效应来调控,就像充满囊肿性纤维化病人肺部铜绿假单胞菌的生物膜一样。
假单胞菌属根据其RNA/DNA的同源性可分为五个主要型,铜绿假单胞菌(Pseudomonas aeruginosa)是其代表菌种。

网上:产朊假丝酵母网:酵母形态观察毕赤酵母网:1600倍放大,可看出此酵母菌大小和红细胞差不多我:我的酵母也同样存在这种一个是内部复杂的结构,一个是内部像鸡蛋一样的简单结构的2种酵母形态,我特别想知道,他们究竟是同一种酵母?还是不同的酵母??后来查到这是一个测试过滤脏水能为能饮用的水的野外微型过滤器的效果,所以,这个酵母菌的不是培养出来的,而是过滤到的,应该是混合菌。
不是纯培养。
一些酵母只有图二的形态,另一些则在单细胞酵母和多细胞细丝状形态之间变化。
事实上,酿酒酵母在恶劣的繁殖条件下也会变成长丝状以便更好的吸收营养。
酵母到底是什么?2013-09-19 08:49 来源:光明网-国际观察频道我有话说图三是白假丝酵母菌,分别有酵母和细丝两种形态:图三,白色念珠菌,也称白假丝酵母菌简而言之,酵母是一种生存状态的别名,而非“鸟类”和“脊椎动物”这种严格的分类法。
1500种真菌在漫长的相似的环境下逐渐获得了类似的生存形态。
这称为趋同进化,是生物学主要的课题之一。
酵母通过不断萌芽来繁殖,比如酿酒酵母此时看起来就像一个鼓囊囊的气球。
图四展示了酵母萌芽:酵母菌可以漂浮在空气中或落在地球上所有表面。
比如一罐打开一段时间的奶油(表面会形奶油色菌落)或者葡萄表面,鲜榨葡萄汁晾着不久便能散发酒味,这也解释了第一杯葡萄酒如何得来。
酵母之所以能制作面包、啤酒和葡萄酒,是因为它可以在无氧环境下利用糖的能量发酵。
发酵产生2个副产品:二氧化碳——使面包鼓起、啤酒充满泡沫;乙醇——赋予啤酒或葡萄酒令人愉悦的口感(制作面包时则会蒸发)。
此过程对这三种食物都非常必要;联想到最初在发霉的小麦堆里闻到了诱人酒香,这也算是微生物赠与人类的大礼。
如今它的身影常出现在热烤箱和食物发酵积液里。
我们几乎可以肯定,若没有酵母革命性的生产,人类食物的历史将彻底改样。
(编译:崔浩)附图1 白色念珠菌-酵母美图酵母菌好实沃全球领先的稳定化耐高温乳酸菌供应商此为糖尿病患者的尿液,沈渣中可看到大量的酵母菌,白血球和细菌...白色念珠菌-第一节白假丝酵母菌Cnki上面查的:放大12000倍的正常热带假丝酵母菌形态图片来源:魏娟. 秸秆醋液抑菌和杀菌性能的研究, 2009>>查看本文图片摘要图片关键词:形态热带假丝酵母菌醋液菌体玉米秆所属学科:有机化工图片上下文:图5-1 放大12000 倍的正常白色念珠菌形态图5-2 放大12000 倍的醋液作用过的白色念珠菌形态Fig.5-1 Normal morphology of C. albicans Fig.5-2 The morphology of C. albicansaffe....>>展开全部∙季军远. 降氰真菌的筛选及其降氰特性研究, 2005>>查看本文图片摘要图片关键词:模式图模式图所属学科:环境科学与资源利用∙图片上下文:图.37酵母菌形态模式图Hahaha ha哈啊哈哈!!我操!真的找到这样的酵母菌了!!!降解氰化物!!∙图片来源:吕丹凤. 基于图像的酵母菌生长分析与筛选技术研究, 2012>>查看本文图片摘要沈楠,肖冬光,吴帅,丁书美,徐曼. 大豆脂肪酸对酿酒酵母酒精耐性的影响, 酿酒科技, 2006 (11). >>查看本文图片摘要图片关键词:沈楠,肖冬光,吴帅,丁书美,徐曼. 大豆脂肪酸对酿酒酵母酒精耐性的影响, 酿酒科技, 2006 (11孙万儒. 酵母菌, 生物学通报, 2007 (11).刘磊,吴晖,刘冬梅,余以刚,李晓凤. 黄酒生产用酵母的分离与筛选, 现代食品科技, 2007 (图片关键词:显微镜细胞形态结论酵母发酵力抗高温这张照片貌似也是两种不同的酵母,颜色深浅不一图274号酵母菌菌落形态及显微形态图263号酵母菌菌落形态及显微形态余翔. 金华火腿现代化发酵工艺中微生物区系研究, 2005>>查看本文图片摘要图片关键词:显微形态菌落形态酵母菌豆芽汁培养基显微形态菌落形态菌落菌体所属学科:轻工业手工业高玲美. 高蛋白海洋酵母的初步研究, 2007>>查看本文图片摘要王麟. 海洋酵母菌种资源库的建立及特殊类型海洋酵母菌的多样性研究, 2008普洱茶中分离的酵母方祥,陈栋,李晶晶,赵超艺,李斌,黄国资,陈忠正. 普洱茶不同贮藏时期微生物种群的鉴定,现代食品科技, 2008 (02)酵母细胞由酵母转化为真菌丝的过程及真菌丝结构吕文洲,刘英,陈和平,朱建林. 氮对酵母菌-SBR系统效能及酵母形态的影响研究, 环境科学, 2008 (05).聚胺酸修饰酵母的扫描电镜的图片许彬彬,佟蜜,孙小梅,李步海. 聚胺酸修饰酵母对碱性品红和亚甲基蓝的吸附行为, 化学工程师, 2008 (06克鲁维毕赤氏酵母42 自然发酵前期的相关酵母本试验发酵第 1 天所筛选的酵母在WL 培养基李梓,王军. 山葡萄酵母菌株的分离及初步鉴定, 食品科技, 2008 (09裂殖酵母在WL培养基上的菌落形态刘树文,王玉霞,陶怀泉,车兆虹,武胜叶. SO_2和酒精处理对葡萄酒自然发酵酵母菌群的影响, 西北农林科技大学学报(自然科学版), 2008 (05).冬虫夏草子实体梁宗琦,韩燕峰,梁建东,董旋,杜文. 冬虫夏草Ophiocordycepssinensis研究中几个值得关注的问题, 微生物学通报, 2010 (11).次甲基蓝染色后的部分酵母菌株细胞显微形态∙徐勇. 木糖代谢关键酶基因克隆及重组酵母菌株构建, 2005类酵母细胞形态的演化∙段效辉. 普鲁兰多糖高产菌株Y68多糖发酵生产及其机理初步研究, 2007固定化酵母的选育及在木薯浓醪发酵生产燃料乙醇中的性能对比伍彦华,覃红梅,崔师泰,盘柳萍,凌成金. 固定化酵母的选育及在木薯浓醪发酵生产燃料乙醇中的性能对比, 酿酒科技, 2010 (07).驯化前后菌株形态比较周稳稳,张永奎,邹文婷,李永红. 圆红冬孢酵母在酒精废水中发酵产油, 化工进展, 2010 (S1又一个环境微生物!菌落形态龚方. 海洋季也蒙毕赤酵母菊粉酶的发酵生产、纯化、特性、基因克隆与表达的研究, 2008海洋嗜杀酵母的菌落形态海洋酵母G7a菌落形态图(A)与细胞形态图(B)海洋嗜杀酵母的细胞形态(1000倍Olympus相差镜头)嗜杀是指拮抗性较强,与其他物种不混生,产生抗生素的性能王麟. 海洋酵母菌种资源库的建立及特殊类型海洋酵母菌的多样性研究, 2008产香酵母51.53菌株个体形态特征图3一12产香酵母515.3菌株菌落形态特征张翠英. 优良果酒酵母的分离选育及发酵性能研究, 2006白念珠菌生物膜在h2时的镜下形态特点(X40)马海丽. 念珠菌致病机制的研究, 2006酵母细胞冷处理细胞核电镜观察箭头所指细胞核形态异常叶岚. 抗凋亡基因抑制酵母冷诱导的细胞凋亡及其调控机制, 2006DissoconiummultiseptataeA-B分生孢子;C-D分生孢子梗及疤痕Fig.3-9DissoconiummultiseptataeA-Bconidia;C-Dconidiophoresandscars∙图片来源:翟晓茹. 苹果果实表皮生态位点病原菌多样性研究, 2008>>查看本文图片摘要图片关键词:生活史疤痕分生孢子梗分生孢子所属学科:植物保护园艺∙图片上下文:32图3-9 DissoconiummultiseptataeA-B 分生孢子;C-D 分生孢子梗及疤痕Fig.3-9 DissoconiummultiseptataeA-B conidia; C-D conidiophores and scars3.4.3 出芽短梗霉属该....显微镜图片(放大1000倍)显微镜图(放大1000倍)佟蜜. 面包酵母的修饰表征及对重金属和染料吸附行为的研究, 2007酶解前(A)和酶解后(B)的酿酒酵母显微形态成志远. 大豆异黄酮转化菌株原生质体制备与融合研究, 2010康氏木霉孢子形态图(100×10)白晓青. 康氏木霉与酿酒酵母原生质体融合构建产酒精新菌株, 2010假丝酵母原生菌菌落形态高鹤. 脂肪酶产生菌的细胞融合选育及其产酶条件优化, 2010酵母形态生长的共生菌菌落研究一下这篇文章,看看,是不是有的微生物培养就很难纯培养??邱振鲁. 石耳科真菌的分离培养及其生物活性的研究, 20114 株酵母菌菌株的镜检结果(100 ×)∙聂凌鸿,樊璐,季方. 大曲中细菌和酵母菌的分离及其Biolog微生物系统分析鉴定, 安徽农业科学, 2012 (02菌株HRZ002的菌落形态∙黄蓉姿. 造纸废水生化处理系统中纤维素降解菌的活性特征研究, 2012扣囊复膜酵母A11和敲除菌株A11-a的菌落及细胞形态王东升. 扣囊复膜酵母A11菌株酸性蛋白酶基因和MIG1基因敲除对酶的生产和海藻积累的影响, 2011酿酒酵母细胞(A)和糠醛耐受酿酒酵母细胞(B)的细胞形态(50X)林凤鸣. 糠醛和苯酚对酵母作用定量蛋白质组学及脂肪酸模块构建, 2011添加Phe0H对Y4#菌培养1od时细胞形态的影响武双. 真菌群体感应分子调控产油酵母的研究, 2008菌株WC43-3.菌落形态图(A)与细胞形态图(B)王致鹏. 汉逊德巴利酵母WC43-3菌株内β-1,3-葡聚糖酶及其基因的研究, 2011海洋酒精酵母菌株2E00558的菌落形态和细胞形态赵新灵. 海洋酒精酵母菌的筛选及酒精酵母菌W0的遗传改造, 2011酿酒酵母(a)及单倍体细胞(b)培养7d后产孢情况(看来这里用到了孢子的染色技术)宋保平. 产甘油假丝酵母生理生化特性、倍性及不同碳源发酵代谢的研究, 2012产甘油假丝酵母形态特征宋保平. 产甘油假丝酵母生理生化特性、倍性及不同碳源发酵代谢的研究, 2012酵母菌ZF -2 分离株的形态学特征A: 菌落; B: 细胞( × 400) ; C: 细胞( × 1000)胡秀彩,戚冰洁,顾丹,梁爽,吕爱军. 斑马鱼肠道中一株红酵母(Rhodotorula)的分离与鉴定, 生物技术, 2011 (04在显微镜放大1600倍得到的S酵母形态图在显微镜放大moo倍得到的T酵母形态图蔡金星. 酱油酿造酵母纯化、生长特性及初步应用研究, 2005柱状假丝酵母形态观察(10×40倍)∙滕宏飞. 固定化酵母细胞制备甘油酯型鱼油, 2011菌株CCNWHX13-160T扫描电镜照片∙郭军康. 铅锌尾矿抗重金属放线菌的分离筛选鉴定, 2008酿酒酵母形态∙江丹. 造纸污泥同步糖化发酵产乙醇的研究, 2010上面酵母形态∙于爱红. 控制上面发酵小麦啤酒中高级醇和乙醛含量的研究, 2011霍方珍. 抗盐酸克伦特罗单链抗体的高效表达及免疫学活性研究, 2007酵母形态显微摄影(600×)∙魏运平. 低产高级醇猕猴桃酒酵母菌株的筛选, 2004F16对猕猴桃汁中野生酵母的嗜杀作用Figure7-4killeractivityoffusantF16towildyeastinkiwifruitjuice罗安伟. 猕猴桃酒生香嗜杀酵母的选育, 2012近十来年,我国猕猴桃酒生产得到了长足发展。
曲霉菌落由于霉菌的菌丝较粗而长,因而霉菌的菌落较大,有的霉菌的菌丝蔓延,没有局限性,其菌落可扩展到整个培养皿,有的种则有一定的局限性,直径1-2厘米或更小。
菌落质地一般比放线菌疏松,外观干燥,不透明,呈现或紧或松的蛛网状、绒毛状或棉絮状;菌落与培养基的连接紧密,不易挑取;菌落正反面的颜色和边缘与中心的颜色常不一致。
霉菌的菌丝。
构成霉菌营养体的基本单位是菌丝。
菌丝是一种管状的细丝,把它放在显微镜下观察,很像一根透明胶管,它的直径一般为3-10微米,比细菌和放线菌的细胞约粗几倍到几十倍。
菌丝可伸长并产生分枝,许多分枝的菌丝相互交织在一起,就叫菌丝体。
枯草芽孢杆菌单个或少数细菌细胞生长繁殖后,会形成以母细胞为中心的一堆肉眼可见、有一定形态构造的子细胞集团,这就是菌落。
细菌菌落常表现为湿润、粘稠、光滑、较透明、易挑取、质地均匀以及菌落正反面或边缘与中央部位颜色一致等。
细菌的菌落特征因种而异。
细菌是单细胞生物,也就是说,一个细胞就是一个个体。
细菌的基本形态有三种:球状、杆状和螺旋状,分别被称为球菌、杆菌和螺旋菌放线菌的菌落:放线菌在固体培养基上形成与细菌不同的菌落特征,放线菌菌丝相互交错缠绕形成质地致密的小菌落,干燥、不透明、难以挑取,当大量孢子覆盖于菌落表面时,就形成表面为粉末状或颗粒状的典型放线菌菌落,由于基内菌丝和孢子常有颜色,使得菌落的正反面呈现出不同的色泽。
酵母菌的菌落大多数酵母菌的菌落特征与细菌相似,但比细菌菌落大而厚,菌落表面光滑、湿润、粘稠,容易挑起,菌落质地均匀,正反面和边缘、中央部位的颜色都很均一,菌落多为乳白色,少数为红色,个别为黑色。
酵母菌是单细胞真核微生物。
酵母菌细胞的形态通常有球形、卵圆形、腊肠形、椭圆形、柠檬形或藕节形等。
比细菌的单细胞个体要大得多,一般为1-5微米×5-30微米。
酵母菌无鞭毛,不能游动。
酵母菌具有典型的真核细胞结构,有细胞壁、细胞膜、细胞核、细胞质、液泡、线粒体等,有的还具有微体。

菌落特征比较总结菌落特征比较:细菌:湿润,粘稠,易挑起放线菌:干燥,多皱,难挑起,菌落较小,多有色素酵母菌:湿润,粘稠,易挑起,表面光华,比细菌的菌落大而厚霉菌:菌丝细长,菌落疏松,成绒毛状、蜘蛛网状、棉絮状,无固定大小,多有光泽,不易挑起细菌:一般形成较小的圆形菌落,颜色有白色、黄色等,表面光滑或不光滑放线菌:菌落背面有同心圆形纹路。
这点可以和细菌菌落区分。
酵母菌:菌落为淡黄色,光滑,半透明,比细菌菌落大。
霉菌:菌落大型,肉眼可见许多毛状物,棕色、青色等,可见黑色的分生孢子群。
对于科学实践中鉴别微生物种类有重要意义。
微生物菌落形态图片 金黄色葡萄球菌在BP 琼脂上典型特征金黄色葡萄球菌呈圆形 , 表面光滑、凸起、湿润 , 直径 2 ~ 3mm 。
灰黑色至黑色 , 有光泽 , 常有浅色 ( 非白色 ) 的边缘 , 周围绕以不透明圈 ( 沉淀 ), 其外常有一清晰带 ( 卵磷脂环 ) 。
当用接种针触及菌落时具有黄油样粘稠感。
有时可见到不分解脂肪的菌株 , 除没有不透明圈和清晰带外 , 其他外观基本相同。
从长期贮存的冷冻或脱水食品中分离的菌落 , 其黑色常较典型菌落浅些 , 且外观可能较粗糙 , 质地较干燥。
金黄色葡萄球菌在海博金黄色葡萄球菌显色培养基上典型特征典型的金黄色葡萄球菌为灰黑色菌落,其外围有一不透明圈。
本培养基用于直接鉴定金黄色葡萄球菌,如果在18-24 小时没有出现典型菌落,需再培养18-24 小时。
有时金黄色葡萄球菌不显灰黑色,但其外围有一不透明圈。
金黄色葡萄球在甘露醇高盐琼脂培养基上典型特征典型特征:金黄色葡萄球菌显黄色,其外围有一黄色的晕环。
大肠杆菌在海博大肠杆菌/大肠杆菌典型菌落为蓝色至紫色,大肠菌群为粉红色菌落,其它细菌为无色菌落。
大肠菌群显色培养基上典型特征大肠菌群在去氧胆酸盐琼脂典型菌落为红色, 菌落周围有红色的胆盐沉淀环。
菌落直径为2-3mm 或更大。
(DC)上典型特征大肠菌群在结晶紫中性红琼典型菌落为紫红色, 菌落周围有红色的胆盐沉淀环。

菌落特征比较
菌落特征比较:
细菌:湿润,粘稠,易挑起
放线菌:干燥,多皱,难挑起,菌落较小,多有色素ﻫ酵母菌:湿润,粘稠,易挑起,表面光华,比细菌得菌落大而厚
霉菌:菌丝细长,菌落疏松,成绒毛状、蜘蛛网状、棉絮状,
无固定大小,多有光泽,不易挑起
ﻫ细菌:一般形成较小得圆形菌落,颜色有白色、黄色等,表面光滑或不光滑ﻫ放线菌:菌落背面有同心圆形纹路。
这点可以与细菌菌落区分。
酵母菌:菌落为淡黄色,光滑,半透明,比细菌菌落大。
ﻫ霉菌:菌落大型,肉眼可见许多毛状物,棕色、青色等,可见黑色得分生孢子群.ﻫﻫ对于科学实践中鉴别微生物种类有重要意义。
微生物菌落形态图片
大肠菌群在去
氧胆酸盐琼脂
典型菌落为红色,菌落周围有红色得胆盐沉淀环。
菌落直径为 2-3mm 或更大。
(DC)上典型
特征
大肠菌群在结
晶紫中性红琼
典型菌落为紫红色 , 菌落周围有红色得胆盐沉淀环。
菌落直径为0.5mm 或更大. 脂(VRBA)
上典型特征
大肠杆菌O1
57菌在海博
典型O157:H7菌显紫色 , 大肠杆菌与大肠菌群显暗蓝色.
O157菌显色
培养基上典型
特征
大肠杆菌在伊
红美蓝琼脂
大肠杆菌呈黑色中心 ,有或无金属光泽、
(EMB)上典型
特征
大肠杆菌在月
大肠杆菌分解乳糖产生气体,有小倒管内收集有气泡.
桂基硫酸盐胰
蛋白胨肉汤(L
在MYP琼脂上典型特征。



微生物菌落形态图片金黄色葡萄球菌在BP琼脂上典型特征金黄色葡萄球菌呈圆形, 表面光滑、凸起、湿润, 直径2 ~3mm 。
灰黑色至黑色, 有光泽, 常有浅色( 非白色) 的边缘, 周围绕以不透明圈( 沉淀), 其外常有一清晰带( 卵磷脂环) 。
当用接种针触及菌落时具有黄油样粘稠感。
有时可见到不分解脂肪的菌株, 除没有不透明圈和清晰带外, 其他外观基本相同。
从长期贮存的冷冻或脱水食品中分离的菌落, 其黑色常较典型菌落浅些, 且外观可能较粗糙, 质地较干燥。
金黄色葡萄球菌在海博金黄色葡萄球菌显色培养基上典型特征典型的金黄色葡萄球菌为灰黑色菌落,其外围有一不透明圈。
本培养基用于直接鉴定金黄色葡萄球菌,如果在18-24 小时没有出现典型菌落,需再培养18-24 小时。
有时金黄色葡萄球菌不显灰黑色,但其外围有一不透明圈。
金黄色葡萄球在甘露醇高盐典型特征:金黄色葡萄球菌显黄色,其外围有一黄色的晕环。
琼脂培养基上典型特征大肠杆菌在海博大肠杆菌/大肠菌群显色大肠杆菌典型菌落为蓝色至紫色,大肠菌群为粉红色菌落,其它细菌为无色菌落。
培养基上典型特征大肠菌群在去氧胆酸盐琼脂典型菌落为红色, 菌落周围有红色的胆盐沉淀环。
菌落直径为2-3mm 或更大。
(DC)上典型特征大肠菌群在结晶紫中性红琼典型菌落为紫红色, 菌落周围有红色的胆盐沉淀环。
菌落直径为0.5mm 或更大。
脂(VRBA)上典型特征大肠杆菌O157菌在海典型O157:H7 菌显紫色,大肠杆菌和大肠菌群显暗蓝色。
博O157菌显色培养基上典型特征大肠杆菌在伊红美蓝琼脂大肠杆菌呈黑色中心,有或无金属光泽.(EMB)上典型特征大肠杆菌在月桂基硫酸盐胰蛋白胨肉汤(LST)上典型特征大肠杆菌分解乳糖产生气体,有小倒管内收集有气泡。
沙门氏菌在海博沙门氏菌显色培养基上典型特征典型沙门氏菌显亮红色,大肠杆菌显蓝色绿色,枸橼酸杆菌显紫色,其它细菌显黄色或无色。
沙门氏菌在胆硫乳琼脂(DHL琼脂)上典型特征沙门氏菌在37 ℃培养22-24 小时后,无色半透明有黑色中心或几乎全为黑色。

微生物菌落形态图片金黄色葡萄球菌在BP琼脂上典型特征金黄色葡萄球菌呈圆形, 表面光滑、凸起、湿润, 直径2 ~3mm 。
灰黑色至黑色, 有光泽, 常有浅色( 非白色) 的边缘, 周围绕以不透明圈( 沉淀), 其外常有一清晰带( 卵磷脂环) 。
当用接种针触及菌落时具有黄油样粘稠感。
有时可见到不分解脂肪的菌株, 除没有不透明圈和清晰带外, 其他外观基本相同。
从长期贮存的冷冻或脱水食品中分离的菌落, 其黑色常较典型菌落浅些, 且外观可能较粗糙, 质地较干燥。
金黄色葡萄球菌在海博金黄色葡萄球菌显色培养基上典型特征典型的金黄色葡萄球菌为灰黑色菌落,其外围有一不透明圈。
本培养基用于直接鉴定金黄色葡萄球菌,如果在18-24 小时没有出现典型菌落,需再培养18-24 小时。
有时金黄色葡萄球菌不显灰黑色,但其外围有一不透明圈。
金黄色葡萄球在甘露醇高盐典型特征:金黄色葡萄球菌显黄色,其外围有一黄色的晕环。
特征大肠杆菌在海博大肠杆菌/大肠菌群显色培养基上典型特征大肠杆菌典型菌落为蓝色至紫色,大肠菌群为粉红色菌落,其它细菌为无色菌落。
大肠菌群在去氧胆酸盐琼脂(DC)上典型特征典型菌落为红色, 菌落周围有红色的胆盐沉淀环。
菌落直径为2-3mm 或更大。
大肠菌群在结晶紫中性红琼脂(VRBA)上典型特征典型菌落为紫红色, 菌落周围有红色的胆盐沉淀环。
菌落直径为0.5mm 或更大。
O157菌在海博O157菌显色培养基上典型特征典型O157:H7 菌显紫色,大肠杆菌和大肠菌群显暗蓝色。
大肠杆菌在伊红美蓝琼脂(EMB)上典型特征大肠杆菌呈黑色中心,有或无金属光泽.大肠杆菌在月桂基硫酸盐胰蛋白胨肉汤(LST)上典型特征大肠杆菌分解乳糖产生气体,有小倒管内收集有气泡。
在海博沙门氏菌显色培养基上典型特征典型沙门氏菌显亮红色,大肠杆菌显蓝色绿色,枸橼酸杆菌显紫色,其它细菌显黄色或无色。
沙门氏菌在胆硫乳琼脂(DHL琼脂)上典型特征沙门氏菌在37 ℃培养22-24 小时后,无色半透明有黑色中心或几乎全为黑色。

微生物菌落形态总结大全微生物菌落形态总结大全微生物菌落形态总结大全微生物菌落特征形态总结大全(带图片)菌落特征比较总结菌落特征比较: 细菌:湿润,粘稠,易挑起放线菌: 干燥,多皱,难挑起,菌落较小,多有色素酵母菌: 湿润,粘稠,易挑起,表面光华,比细菌的菌落大而厚霉菌:菌丝细长,菌落疏松,成绒毛状、蜘蛛网状、棉絮状,无固定大小,多有光泽,不易挑起细菌:一般形成较小的圆形菌落,颜色有白色、黄色等,表面光滑或不光滑放线菌: 菌落背面有同心圆形纹路。
这点可以和细菌菌落区分。
酵母菌: 菌落为淡黄色,光滑,半透明,比细菌菌落大。
霉菌: 菌落大型,肉眼可见许多毛状物,棕色、青色等,可见黑色的分生孢子群。
对于科学实践中鉴别微生物种类有重要意义。
微生物菌落形态图片微生物菌落特征形态总结大全(带图片)菌落特征比较总结菌落特征比较: 细菌:湿润,粘稠,易挑起放线菌: 干燥,多皱,难挑起,菌落较小,多有色素酵母菌: 湿润,粘稠,易挑起,表面光华,比细菌的菌落大而厚霉菌:菌丝细长,菌落疏松,成绒毛状、蜘蛛网状、棉絮状,无固定大小,多有光泽,不易挑起细菌:一般形成较小的圆形菌落,颜色有白色、黄色等,表面光滑或不光滑放线菌: 菌落背面有同心圆形纹路。
这点可以和细菌菌落区分。
酵母菌: 菌落为淡黄色,光滑,半透明,比细菌菌落大。
霉菌: 菌落大型,肉眼可见许多毛状物,棕色、青色等,可见黑色的分生孢子群。
对于科学实践中鉴别微生物种类有重要意义。
微生物菌落形态图片篇三:实验五微生物菌落形态观察实验五微生物菌落形态观察1、本次实验的目的和要求(1)观察细菌、酵母菌、霉菌三大类微生物具体菌落的形态特征。
(2)总结三类微生物菌落的一般特征并能识别。
(特征描述: 形状、大小、颜色、边缘、隆起、光泽、质地等。
)2、实验内容或原理菌落: 单个菌体在固体平面培养基上生长繁殖形成的肉眼可见的群体。
区分和识别各类微生物可从菌落形态(群体形态)和细胞形态(个体形态)两方面进行,菌落形态是无数细胞形态的集中反映,因此每一大类微生物都有其一定的菌落特征,可通过这些特征差异区分和识别。

微生物菌落形态总结大全微生物菌落形态总结大全微生物菌落形态总结大全篇一:微生物菌落特征形态总结大全(带图片) 菌落特征比较总结菌落特征比较: 细菌:湿润,粘稠,易挑起放线菌:干燥,多皱,难挑起,菌落较小,多有色素酵母菌:湿润,粘稠,易挑起,表面光华,比细菌的菌落大而厚霉菌:菌丝细长,菌落疏松,成绒毛状、蜘蛛网状、棉絮状,无固定大小,多有光泽,不易挑起细菌:一般形成较小的圆形菌落,颜色有白色、黄色等,表面光滑或不光滑放线菌: 菌落背面有同心圆形纹路。
这点可以和细菌菌落区分。
酵母菌:菌落为淡黄色,光滑,半透明,比细菌菌落大。
霉菌:菌落大型,肉眼可见许多毛状物,棕色、青色等,可见黑色的分生孢子群。
对于科学实践中鉴别微生物种类有重要意义。
微生物菌落形态图片篇二:微生物菌落特征形态总结大全(带图片) 菌落特征比较总结菌落特征比较: 细菌:湿润,粘稠,易挑起放线菌:干燥,多皱,难挑起,菌落较小,多有色素酵母菌:湿润,粘稠,易挑起,表面光华,比细菌的菌落大而厚霉菌:菌丝细长,菌落疏松,成绒毛状、蜘蛛网状、棉絮状,无固定大小,多有光泽,不易挑起细菌:一般形成较小的圆形菌落,颜色有白色、黄色等,表面光滑或不光滑放线菌: 菌落背面有同心圆形纹路。
这点可以和细菌菌落区分。
酵母菌:菌落为淡黄色,光滑,半透明,比细菌菌落大。
霉菌:菌落大型,肉眼可见许多毛状物,棕色、青色等,可见黑色的分生孢子群。
对于科学实践中鉴别微生物种类有重要意义。
微生物菌落形态图片篇三:实验五微生物菌落形态观察实验五微生物菌落形态观察1、本次实验的目的和要求(1)观察细菌、酵母菌、霉菌三大类微生物具体菌落的形态特征。
(2)总结三类微生物菌落的一般特征并能识别。
(特征描述:形状、大小、颜色、边缘、隆起、光泽、质地等。
)2、实验内容或原理菌落:单个菌体在固体平面培养基上生长繁殖形成的肉眼可见的群体。
区分和识别各类微生物可从菌落形态(群体形态)和细胞形态(个体形态)两方面进行,菌落形态是无数细胞形态的集中反映,因此每一大类微生物都有其一定的菌落特征,可通过这些特征差异区分和识别。
菌落特征比较总结菌落特征比较:细菌:湿润,粘稠,易挑起放线菌:干燥,多皱,难挑起,菌落较小,多有色素酵母菌:湿润,粘稠,易挑起,表面光华,比细菌的菌落大而厚霉菌:菌丝细长,菌落疏松,成绒毛状、蜘蛛网状、棉絮状,无固定大小,多有光泽,不易挑起细菌:一般形成较小的圆形菌落,颜色有白色、黄色等,表面光滑或不光滑放线菌:菌落背面有同心圆形纹路。
这点可以和细菌菌落区分。
酵母菌:菌落为淡黄色,光滑,半透明,比细菌菌落大。
霉菌:菌落大型,肉眼可见许多毛状物,棕色、青色等,可见黑色的分生孢子群。
对于科学实践中鉴别微生物种类有重要意义。
微生物菌落形态图片金黄色葡萄球菌在BP琼脂上典型特征金黄色葡萄球菌呈圆形, 表面光滑、凸起、湿润, 直径2 ~3mm 。
灰黑色至黑色, 有光泽, 常有浅色( 非白色) 的边缘, 周围绕以不透明圈( 沉淀), 其外常有一清晰带( 卵磷脂环) 。
当用接种针触及菌落时具有黄油样粘稠感。
有时可见到不分解脂肪的菌株, 除没有不透明圈和清晰带外, 其他外观基本相同。
从长期贮存的冷冻或脱水食品中分离的菌落, 其黑色常较典型菌落浅些, 且外观可能较粗糙, 质地较干燥。
金黄色葡萄球菌在海博金黄色葡萄球菌显色培养基上典型特征典型的金黄色葡萄球菌为灰黑色菌落,其外围有一不透明圈。
本培养基用于直接鉴定金黄色葡萄球菌,如果在18-24 小时没有出现典型菌落,需再培养18-24 小时。
有时金黄色葡萄球菌不显灰黑色,但其外围有一不透明圈。
金黄色葡萄球在甘露醇高盐典型特征:金黄色葡萄球菌显黄色,其外围有一黄色的晕环。
琼脂培养基上典型特征大肠杆菌在海博大肠杆菌/大肠菌群显色大肠杆菌典型菌落为蓝色至紫色,大肠菌群为粉红色菌落,其它细菌为无色菌落。
培养基上典型特征大肠菌群在去氧胆酸盐琼脂典型菌落为红色, 菌落周围有红色的胆盐沉淀环。
菌落直径为2-3mm 或更大。
(DC)上典型特征大肠菌群在结晶紫中性红琼典型菌落为紫红色, 菌落周围有红色的胆盐沉淀环。
菌落特征比较总结菌落特征比较:细菌:湿润,粘稠,易挑起放线菌:干燥,多皱,难挑起,菌落较小,多有色素酵母菌:湿润,粘稠,易挑起,表面光华,比细菌的菌落大而厚霉菌:菌丝细长,菌落疏松,成绒毛状、蜘蛛网状、棉絮状,无固定大小,多有光泽,不易挑起细菌:一般形成较小的圆形菌落,颜色有白色、黄色等,表面光滑或不光滑放线菌:菌落背面有同心圆形纹路。
这点可以与细菌菌落区分。
酵母菌:菌落为淡黄色,光滑,半透明,比细菌菌落大。
霉菌:菌落大型,肉眼可见许多毛状物,棕色、青色等,可见黑色的分生孢子群。
对于科学实践中鉴别微生物种类有重要意义。
微生物菌落形态图片金黄色葡萄球菌在BP琼脂上典型特征金黄色葡萄球菌呈圆形, 表面光滑、凸起、湿润, 直径2 ~3mm 。
灰黑色至黑色, 有光泽, 常有浅色( 非白色) 的边缘, 周围绕以不透明圈( 沉淀), 其外常有一清晰带( 卵磷脂环) 。
当用接种针触及菌落时具有黄油样粘稠感。
有时可见到不分解脂肪的菌株, 除没有不透明圈与清晰带外, 其她外观基本相同。
从长期贮存的冷冻或脱水食品中分离的菌落, 其黑色常较典型菌落浅些, 且外观可能较粗糙, 质地较干燥。
金黄色葡萄球菌在海博金黄色葡萄球菌显色培养基上典型特征典型的金黄色葡萄球菌为灰黑色菌落,其外围有一不透明圈。
本培养基用于直接鉴定金黄色葡萄球菌,如果在18-24 小时没有出现典型菌落,需再培养18-24 小时。
有时金黄色葡萄球菌不显灰黑色,但其外围有一不透明圈。
金黄色葡萄球在甘露醇高盐典型特征:金黄色葡萄球菌显黄色, 其外围有一黄色的晕环。
琼脂培养基上典型特征大肠杆菌在海博大肠杆菌/大肠菌群显色大肠杆菌典型菌落为蓝色至紫色,大肠菌群为粉红色菌落,其它细菌为无色菌落。
培养基上典型特征大肠菌群在去氧胆酸盐琼脂典型菌落为红色, 菌落周围有红色的胆盐沉淀环。
菌落直径为2-3mm 或更大。
(DC)上典型特征大肠菌群在结晶紫中性红琼典型菌落为紫红色, 菌落周围有红色的胆盐沉淀环。
微生物菌落形态图片
金黄色葡萄球菌在BP琼脂上典型特征金黄色葡萄球菌呈圆形, 表面光滑、凸起、湿润, 直径2 ~3mm 。
灰黑色至黑色, 有光泽, 常有浅色( 非白色) 的边缘, 周围绕以不透明圈( 沉淀), 其外常有一清晰带( 卵磷脂环) 。
当用接种针触及菌落时具有黄油样粘稠感。
有时可见到不分解脂肪的菌株, 除没有不透明圈和清晰带外, 其他外观基本相同。
从长期贮存的冷冻或脱水食品中分离的菌落, 其黑色常较典型菌落浅些, 且外观可能较粗糙, 质地较干燥。
金黄色葡萄球菌在海博金黄色葡萄球菌显色培养基上典型特征典型的金黄色葡萄球菌为灰黑色菌落,其外围有一不透明圈。
本培养基用于直接鉴定金黄色葡萄球菌,如果在18-24 小时没有出现典型菌落,需再培养18-24 小时。
有时金黄色葡萄球菌不显灰黑色,但其外围有一不透明圈。
金黄色葡萄球
在甘露醇高盐
典型特征:金黄色葡萄球菌显黄色,其外围有一黄色的晕环。
琼脂培养基上
典型特征
大肠杆菌在海
博大肠杆菌/
大肠菌群显色
大肠杆菌典型菌落为蓝色至紫色,大肠菌群为粉红色菌落,其它细菌为无色菌落。
培养基上典型
特征
大肠菌群在去
氧胆酸盐琼脂
典型菌落为红色, 菌落周围有红色的胆盐沉淀环。
菌落直径为2-3mm 或更大。
(DC)上典型
特征
大肠菌群在结
晶紫中性红琼
典型菌落为紫红色, 菌落周围有红色的胆盐沉淀环。
菌落直径为0.5mm 或更大。
脂(VRBA)上
典型特征
大肠杆菌
O157菌在海
典型O157:H7 菌显紫色,大肠杆菌和大肠菌群显暗蓝色。
博O157菌显
色培养基上典
型特征
大肠杆菌在伊
红美蓝琼脂
大肠杆菌呈黑色中心,有或无金属光泽.
(EMB)上典型
特征
大肠杆菌在月
桂基硫酸盐胰
蛋白胨肉汤
(LST)上典型
特征
大肠杆菌分解乳糖产生气体,有小倒管内收集有气泡。
沙门氏菌在海
博沙门氏菌显色培养基上典型特征典型沙门氏菌显亮红色,大肠杆菌显蓝色绿色,枸橼酸杆菌显紫色,其它细菌显黄色或无色。
沙门氏菌在胆
硫乳琼脂(DHL琼脂)上典型特征沙门氏菌在37 ℃培养22-24 小时后,无色半透明有黑色中心或几乎全为黑色。
有些菌株无色半透明。
沙门氏菌在亚硫酸铋琼脂(BS琼脂)上典型特征沙门氏菌在37 ℃培养24-48 小时后,棕褐色或灰色至黑色,有时有金属光泽,周围培养基呈棕色或黑色,有些菌株呈灰绿色, 周围培养基不变或微变暗。
沙门氏菌在XLD琼脂上典型特征沙门氏菌在35 ℃培养24-48 小时后,无色半透明有黑色中心或几乎全为黑色。
志贺氏菌为无色透明菌落。
大肠杆菌为黄色菌落,其外围有黄色环。
沙门氏菌在SS琼脂上典型特征沙门氏菌在37 ℃培养18-24 小时后,无色透明菌落有黑色中心;志贺氏菌呈无色透明菌落。
沙门氏菌在HE琼脂上典型特征在37 ℃培养18-24 小时后,沙门氏菌、亚利桑那菌和变形杆菌为蓝绿色至蓝色、有或无黑色中心的菌落;大肠杆菌和大肠菌群为粉红色菌落,有沉淀环;,无色半透明有黑色中心或几乎全为黑色。
志贺氏菌和普罗菲登斯菌为绿色、湿润而隆起菌落。
单增李斯特氏菌在海博李斯特氏菌显色培养基上典型特征单增李斯特氏菌37 ℃培养24-28 小时,平板上出现蓝色菌落,菌落周围有一不透明环。
绵羊李斯特氏菌37 ℃培养48 小时,平板上出现蓝色菌落,菌落周围有一不透明环。
西尔李斯特氏菌37 ℃培养24-48 小时,平板上出现蓝色菌落,菌落周围没有不透明环。
在食品检测中绵羊李斯特氏菌非常少见。
李斯特氏菌在
李斯特氏菌在35 ℃培养24-48 小时后,灰绿色菌落。
其外围有一黑色环。
PALCAM琼
脂上典型特征
霉菌在孟加拉
霉菌在孟加拉红培养基上典型特征为灰色菌落,有黑色孢子。
红培养基上典
型特征
酵母菌在孟加
酵母菌在孟加拉红培养基上典型特征为红色菌落。
拉红培养基上
典型特征
酵母菌在马铃
薯葡萄糖琼脂
上典型特征
酵母菌在马铃薯葡萄糖琼脂上在28 ℃培养48 小时后,乳白色菌落,有突起。
副溶血性弧菌
在海博弧菌显
色培养基上典
型特征
典型副溶血性弧菌显蓝色至蓝绿色,霍乱弧菌和其它弧菌显无色。
副溶血性弧菌在TCBS培养基上典型特征典型霍乱弧菌菌落为黄色,扁平,真径2-3mm ;副溶血弧菌菌落呈圆形, 边缘整齐、湿润、稍混浊、半透明,多数具尖心、斗笠状,蓝绿色菌落,直径2-4mm 。
蜡样芽孢杆菌
典型特征:蜡样芽孢杆菌显白色,其外围有粉红色的晕环。
在MYP琼脂
上典型特征。